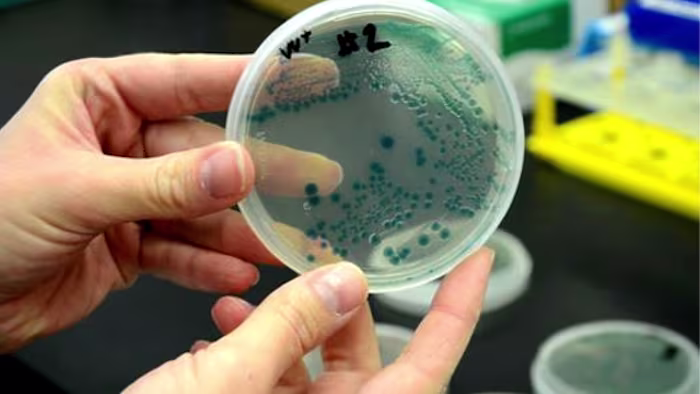
Featured image for Flesh-Eating Bacteria Causes Multiple Deaths in Florida Coastal Waters in 2025

Ross and Griffin Push South Florida as the Next Business Hub
Billionaires Stephen Ross and Ken Griffin, who relocated from New York and Chicago to South Florida, are launching a $10 million campaign called Ambition Accelerated with the Florida Council of 100 to attract more businesses to the Gold Coast (Miami, Fort Lauderdale, West Palm Beach). They argue Florida offers superior business conditions—talent, regulatory predictability, cost structure, and quality of life—and are aiming to lure tech and finance firms while continuing investments in local projects such as Vanderbilt University’s campus, a private school, and a Cleveland Clinic hospital.